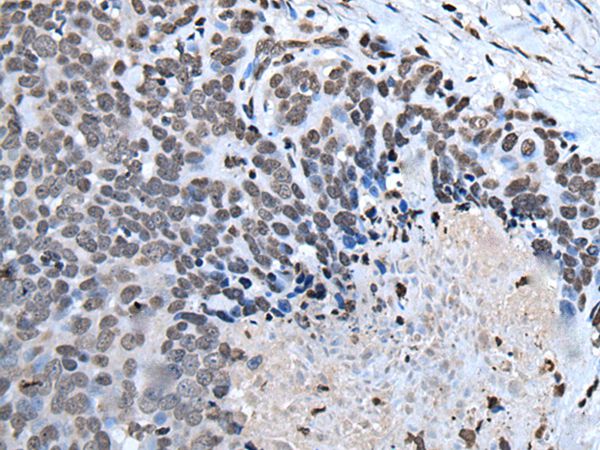

Immunofluorescent staining of human cell line RT4 shows localization to nucleoplasm.
Anti-HOXD1 Antibody
HPA056900
ApplicationsImmunoCytoChemistry
Product group Antibodies
ReactivityHuman
TargetHOXD1
Overview
- SupplierAtlas Antibodies
- Product NameAnti-HOXD1
- Delivery Days Customer4
- ApplicationsImmunoCytoChemistry
- CertificationResearch Use Only
- ClonalityPolyclonal
- ConjugateUnconjugated
- Gene ID3231
- Target nameHOXD1
- Target descriptionhomeobox D1
- Target synonymsHOX4, HOX4G, Hox-4.7, homeobox protein Hox-D1, homeo box 4G, homeo box D1, homeobox protein Hox-GG
- HostRabbit
- IsotypeIgG
- Protein IDQ9GZZ0
- Protein NameHomeobox protein Hox-D1
- Scientific DescriptionRecombinant Protein Epitope Signature Tag (PrEST) antigen sequence
- ReactivityHuman
- Storage Instruction-20°C,2°C to 8°C
- UNSPSC41116161